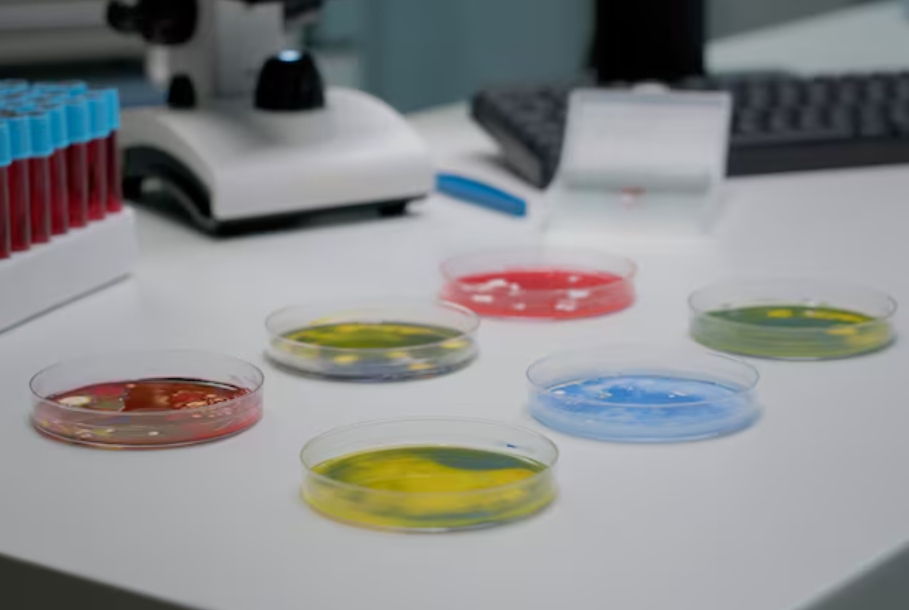
Primary Antibody From Antigen to Laboratory Reagent

Primary Antibody Origins: From Antigen to Laboratory Reagent
2026-01-22
By admin
In today’s pathology labs, clear staining on tissue slides has become something people expect without much thought. But the path a primary antibody takes—the key tool that spots specific markers—runs from a basic biological idea to a reliable lab product. Companies like Celnovte build their work around improving accuracy in cancer testing and helping patients in real ways. Knowing how these antibodies get made matters a great deal for any lab that wants consistent results and trustworthy clinical findings.
The Biological Blueprint: Understanding the Antigen-Antibody Interaction
Every primary antibody starts with picking out a target protein, known as an antigen, tied to a certain disease or cell activity. In cancer work, these targets often show up in higher amounts or changed forms inside tumor cells.
Defining the Target: The Critical Role of Antigen Selection
The process kicks off by choosing a pure antigen that can spark a strong immune reaction. This material has to be prepared in a way that highlights the exact binding sites likely to appear in fixed tissue samples. At Celnovte, creating IVD-grade primary antibodies centers on targets that give clear, useful information for doctors.
Monoclonal vs. Polyclonal: Why Specificity Reigns in Diagnostics
Polyclonal antibodies come from several B-cell lines and bind to various sites on the antigen. In contrast, monoclonal antibodies (MAbs) stand as the preferred choice for clinical IHC work. They trace back to one single B-cell line, so every antibody molecule stays the same. This setup delivers the sharp targeting needed to tell apart similar proteins. That sharp focus forms a core part of Celnovte’s research efforts.
From Concept to Clone: The Manufacturing Platforms of Celnovte
Celnovte Biotech, a high-tech company started in 2010, has set up strong systems for finding new antibodies. The main office sits in Zhengzhou, China, while research teams work in the USA. The company runs two main approaches for building antibodies.
Hybridoma Technology: The Foundation of Murine Monoclonals
The classic mouse-based monoclonal method depends on hybridoma technology. Scientists join antibody-making B-cells from vaccinated mice with endlessly growing myeloma cells. These fused cells act like ongoing production units for high-grade antibodies. Celnovte has produced close to 80 antibodies this way, covering key markers such as ER (Estrogen Receptor), PR (Progesterone Receptor), and HER2.

Single B-Cell Method: The Frontier of Human Monoclonal Development
To raise detection levels even higher, Celnovte uses a human monoclonal approach built on the single B-cell technique. This newer method pulls high-binding antibody genes straight from separate B-cells. The antibodies that come out often show better attachment traits. Those stronger traits prove especially helpful when spotting rare targets in crowded tissue settings.
Engineering Precision: Stability and Consistency in Reagent Production
After finding a strong clone, the next stage centers on producing large amounts without losing quality.
Mammalian Cell Expression: Ensuring Low Batch-to-Batch Variation
Celnovte runs a steady engineering system that uses custom high-output vectors and effective mammal cell lines. Older ways sometimes caused shifts over time, but this modern setup keeps each new batch matching the previous ones. Such steady output offers a major benefit for clinical labs, where differences between batches can lead to serious mistakes in readings.
The Transition to Ready-to-Use (RTU) Formulations
Many primary antibodies get turned into “Ready-to-Use” versions to make lab work smoother. Celnovte supplies more than 400 ready-to-use primary antibodies. These come pre-mixed at the right strength to give strong signals with little background noise, especially on automated machines like the CNT 360 or CNT 320 high-throughput stainers.
Featured Celnovte Primary Antibodies: Setting the Gold Standard
The real proof of antibody quality shows up in everyday lab use. Celnovte offers more than 120 self-cloned MMab and RMab primary antibodies.
ER, PR, and HER2: The “Optimal” Performers in Global Quality Control
The key breast cancer markers—ER (clone C4F11), PR (clone C4D10), and HER2 (clone C1F7)—stand out as strong examples of Celnovte’s technical skill. These antibodies regularly earn “Optimal” or “Good” scores from NordiQC, a respected external review group. For instance, the ER antibody has held an “Optimal” score for six years in a row. That long record points to the lasting steadiness of the company’s production system.

Innovative Targets: The Story of PCNP and Academic Collaboration
Beyond common markers, Celnovte teams up with top research groups. One such partnership with Professor Ji Xinying’s group at Henan University led to the mouse anti-human PCNP (clone C7F1). PCNP is a protein found in the cell nucleus that helps control growth cycles. It shows promise as a fresh marker for diagnosis and treatment in several cancers. Working closely with academics means these antibodies go through tough independent checks before they reach labs.
Validation and Quality Assurance: Bridging the Lab and the Clinic
An antibody proves its worth through solid testing data. Celnovte follows strict quality steps that meet GMP standards to deliver reliable clinical tools.
The Significance of NordiQC Assessments and NMPA Certifications
Outside reviews play a big role in building trust. Along with the strong NordiQC results, several Celnovte antibodies, including the ER one, hold Class III approvals from the NMPA. Those approvals reflect thorough testing and high detection power. Right now, 41 of the company’s own clones have gained top NordiQC marks.
Maintaining Rigor through GMP-Compliant Manufacturing
Production takes place in modern cleanrooms rated at grade 10,000 and 100,000, covering more than 10,000 square meters. The sites hold ISO13485 and ISO9001 certifications. This strict oversight guides every step from antigen to finished reagent. With products in over 2300 leading hospitals across China and use in more than 40 countries, Celnovte reagents have earned widespread confidence through their careful production roots.
In conclusion, a primary antibody stands as much more than a simple lab chemical. It is a finely crafted biological instrument. By handling the full process from early clone creation to large-scale mammal cell growth, Celnovte supplies the pathology field with the exact tools needed for advanced cancer testing.
FAQ
Q: What is the main advantage of Celnovte’s self-cloned primary antibodies?
A: They offer high sensitivity and batch-to-batch consistency, with 41 clones having earned “Optimal” or “Good” ratings in NordiQC assessments.
Q: Are Celnovte primary antibodies compatible with automated staining systems?
A: Yes, we offer over 400 Ready-to-Use (RTU) antibodies specifically optimized for both manual use and fully automated IHC stainers like the CNT 360.
Q: What certifications do Celnovte manufacturing facilities hold?
A: Our facilities are NMPA and GMP compliant, and are certified under ISO13485, ISO9001, FDA, and CE IVDR standards.
Q: Does Celnovte provide antibodies for rapid intraoperative diagnostics?
A: Yes, we offer specialized reagents for fast frozen IHC that can complete the staining process in as little as 10 to 15 minutes.


